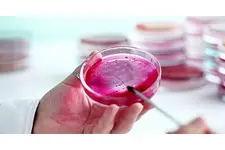
Ferritin Nasıl Yükseltilir? Ferritin Nasıl Yükseltilir?
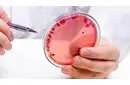
Ferritin Nedir? Ferritin Nedir?

Bebeklerde Ferritin Eksikliği Tedavisi
Bebeklerde ferritin eksikliği, demir yetersizliğine bağlı olarak anemiye yol açabilen bir durumdur. Bu yazıda, ferritinin işlevi, eksikliğinin nedenleri, belirtileri ve tedavi yöntemleri ele alınmaktadır. Sağlıklı gelişim için ferritin seviyelerinin izlenmesi büyük önem taşır.
Bebeklerde Ferritin Eksikliği TedavisiBebeklerin sağlıklı gelişimi için demir, hayati öneme sahip bir mineral olup, ferritin, vücuttaki demir depolama işlevini gerçekleştiren bir proteindir. Ferritin eksikliği, bebeklerde demir yetersizliğine yol açarak anemiye sebep olabilir. Bu durum, bebeklerin büyüme ve gelişim süreçlerinde olumsuz etkilere neden olabilir. Bu yazıda, bebeklerde ferritin eksikliğinin nedenleri, belirtileri ve tedavi yöntemleri üzerinde durulacaktır. Ferritin Nedir? Ferritin, vücuttaki demir depolarını yönetmekten sorumlu bir protein kompleksidir. Vücutta yeterli demir seviyeleri olduğunda, ferritin demiri depolar; demir seviyeleri düştüğünde ise, ferritin serbest demiri serbest bırakır. Ferritin düzeyleri, vücudun demir durumunu gösteren önemli bir belirteçtir. Bebeklerde ferritin seviyeleri, doğumdan sonra ilk birkaç ay içerisinde anneden gelen demir stoklarına dayanır. Ancak bu stoklar, zamanla azalır ve bebeklerin dışarıdan demir alımı gereksinimi artar. Bebeklerde Ferritin Eksikliğinin Nedenleri Bebeklerde ferritin eksikliği, çeşitli nedenlerden kaynaklanabilir:
Ferritin Eksikliğinin Belirtileri Bebeklerde ferritin eksikliği, çeşitli belirtilerle kendini gösterebilir:
Bebeklerde Ferritin Eksikliği Tedavi Yöntemleri Ferritin eksikliği tedavisinde, demir takviyeleri ve beslenme düzenlemeleri önemli rol oynamaktadır:
Sonuç Bebeklerde ferritin eksikliği, ciddi sağlık sorunlarına yol açabilecek bir durumdur. Bu nedenle, belirtilerin erken fark edilmesi ve uygun tedavi yöntemlerinin uygulanması büyük önem taşımaktadır. Ebeveynler, bebeklerinin beslenme düzenlerini dikkatlice izlemeli ve gerekirse bir sağlık uzmanına danışmalıdır. Ferritin seviyelerinin düzenli olarak takip edilmesi, bebeklerin sağlıklı bir büyüme ve gelişim süreci geçirmeleri için kritik bir adımdır. Ek bilgiler: Bebeklerde ferritin düzeylerinin değerlendirilmesi için kan testleri yapılmaktadır. Ferritin düzeylerinin normal aralığı, yaşa ve beslenme durumuna göre değişiklik gösterebilir. Özellikle prematüre bebeklerde veya yüksek risk grubundaki bebeklerde ferritin seviyelerinin izlenmesi daha da önemlidir. |

Bebeğimde sürekli saç dökülmesi ve soluk cilt fark ettim, bu ferritin eksikliği belirtisi olabilir mi? Ferritin testi yaptırmak için hangi durumlarda hekime başvurmalıyım?
Merhaba Şener,
Bebeğinizde saç dökülmesi ve soluk cilt gibi belirtiler, ferritin eksikliği dahil olmak üzere bazı besin eksikliklerinin bir işareti olabilir. Ferritin, vücutta demirin depolanmasında önemli bir rol oynar ve eksikliği demir eksikliğine yol açabilir. Bu tür belirtiler gözlemlediğinizde bir çocuk doktoruna başvurmanız önemlidir. Doktor, bebeğinizin genel sağlığını değerlendirdikten sonra gerekli görürse kan testleri, dahil olmak üzere ferritin testi isteyebilir. Doktorun önerileri doğrultusunda hareket ederek, bebeğinizin ihtiyaç duyduğu tedavi ve bakımı sağlayabilirsiniz. Sağlıklı günler dilerim.